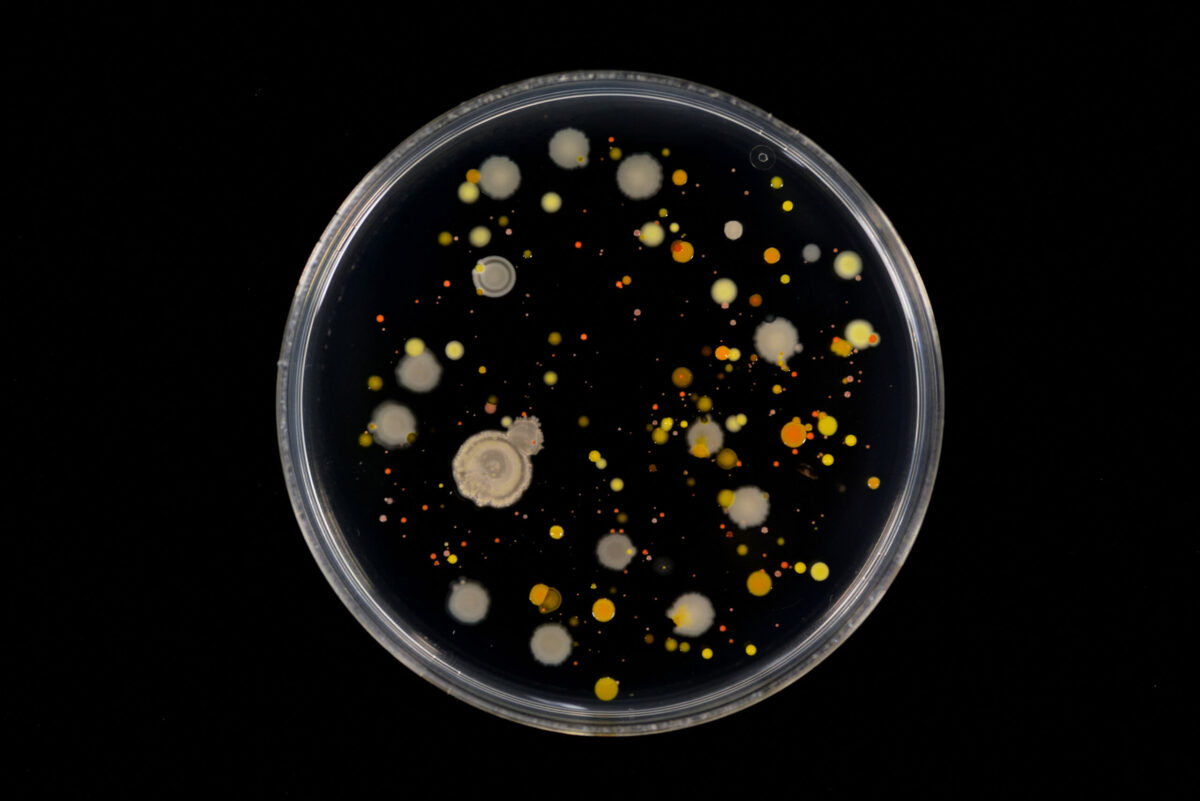

A health condition that causes vertigo, tinnitus (ringing in the ear), and hearing loss is called Meniere’s disease. This condition is quite rare and it often impacts one ear only. Mostly, this ear condition progresses slowly and hearing loss can be permanent. It is called Meniere’s disease after a French doctor (Prosper Meniere). He identified […]